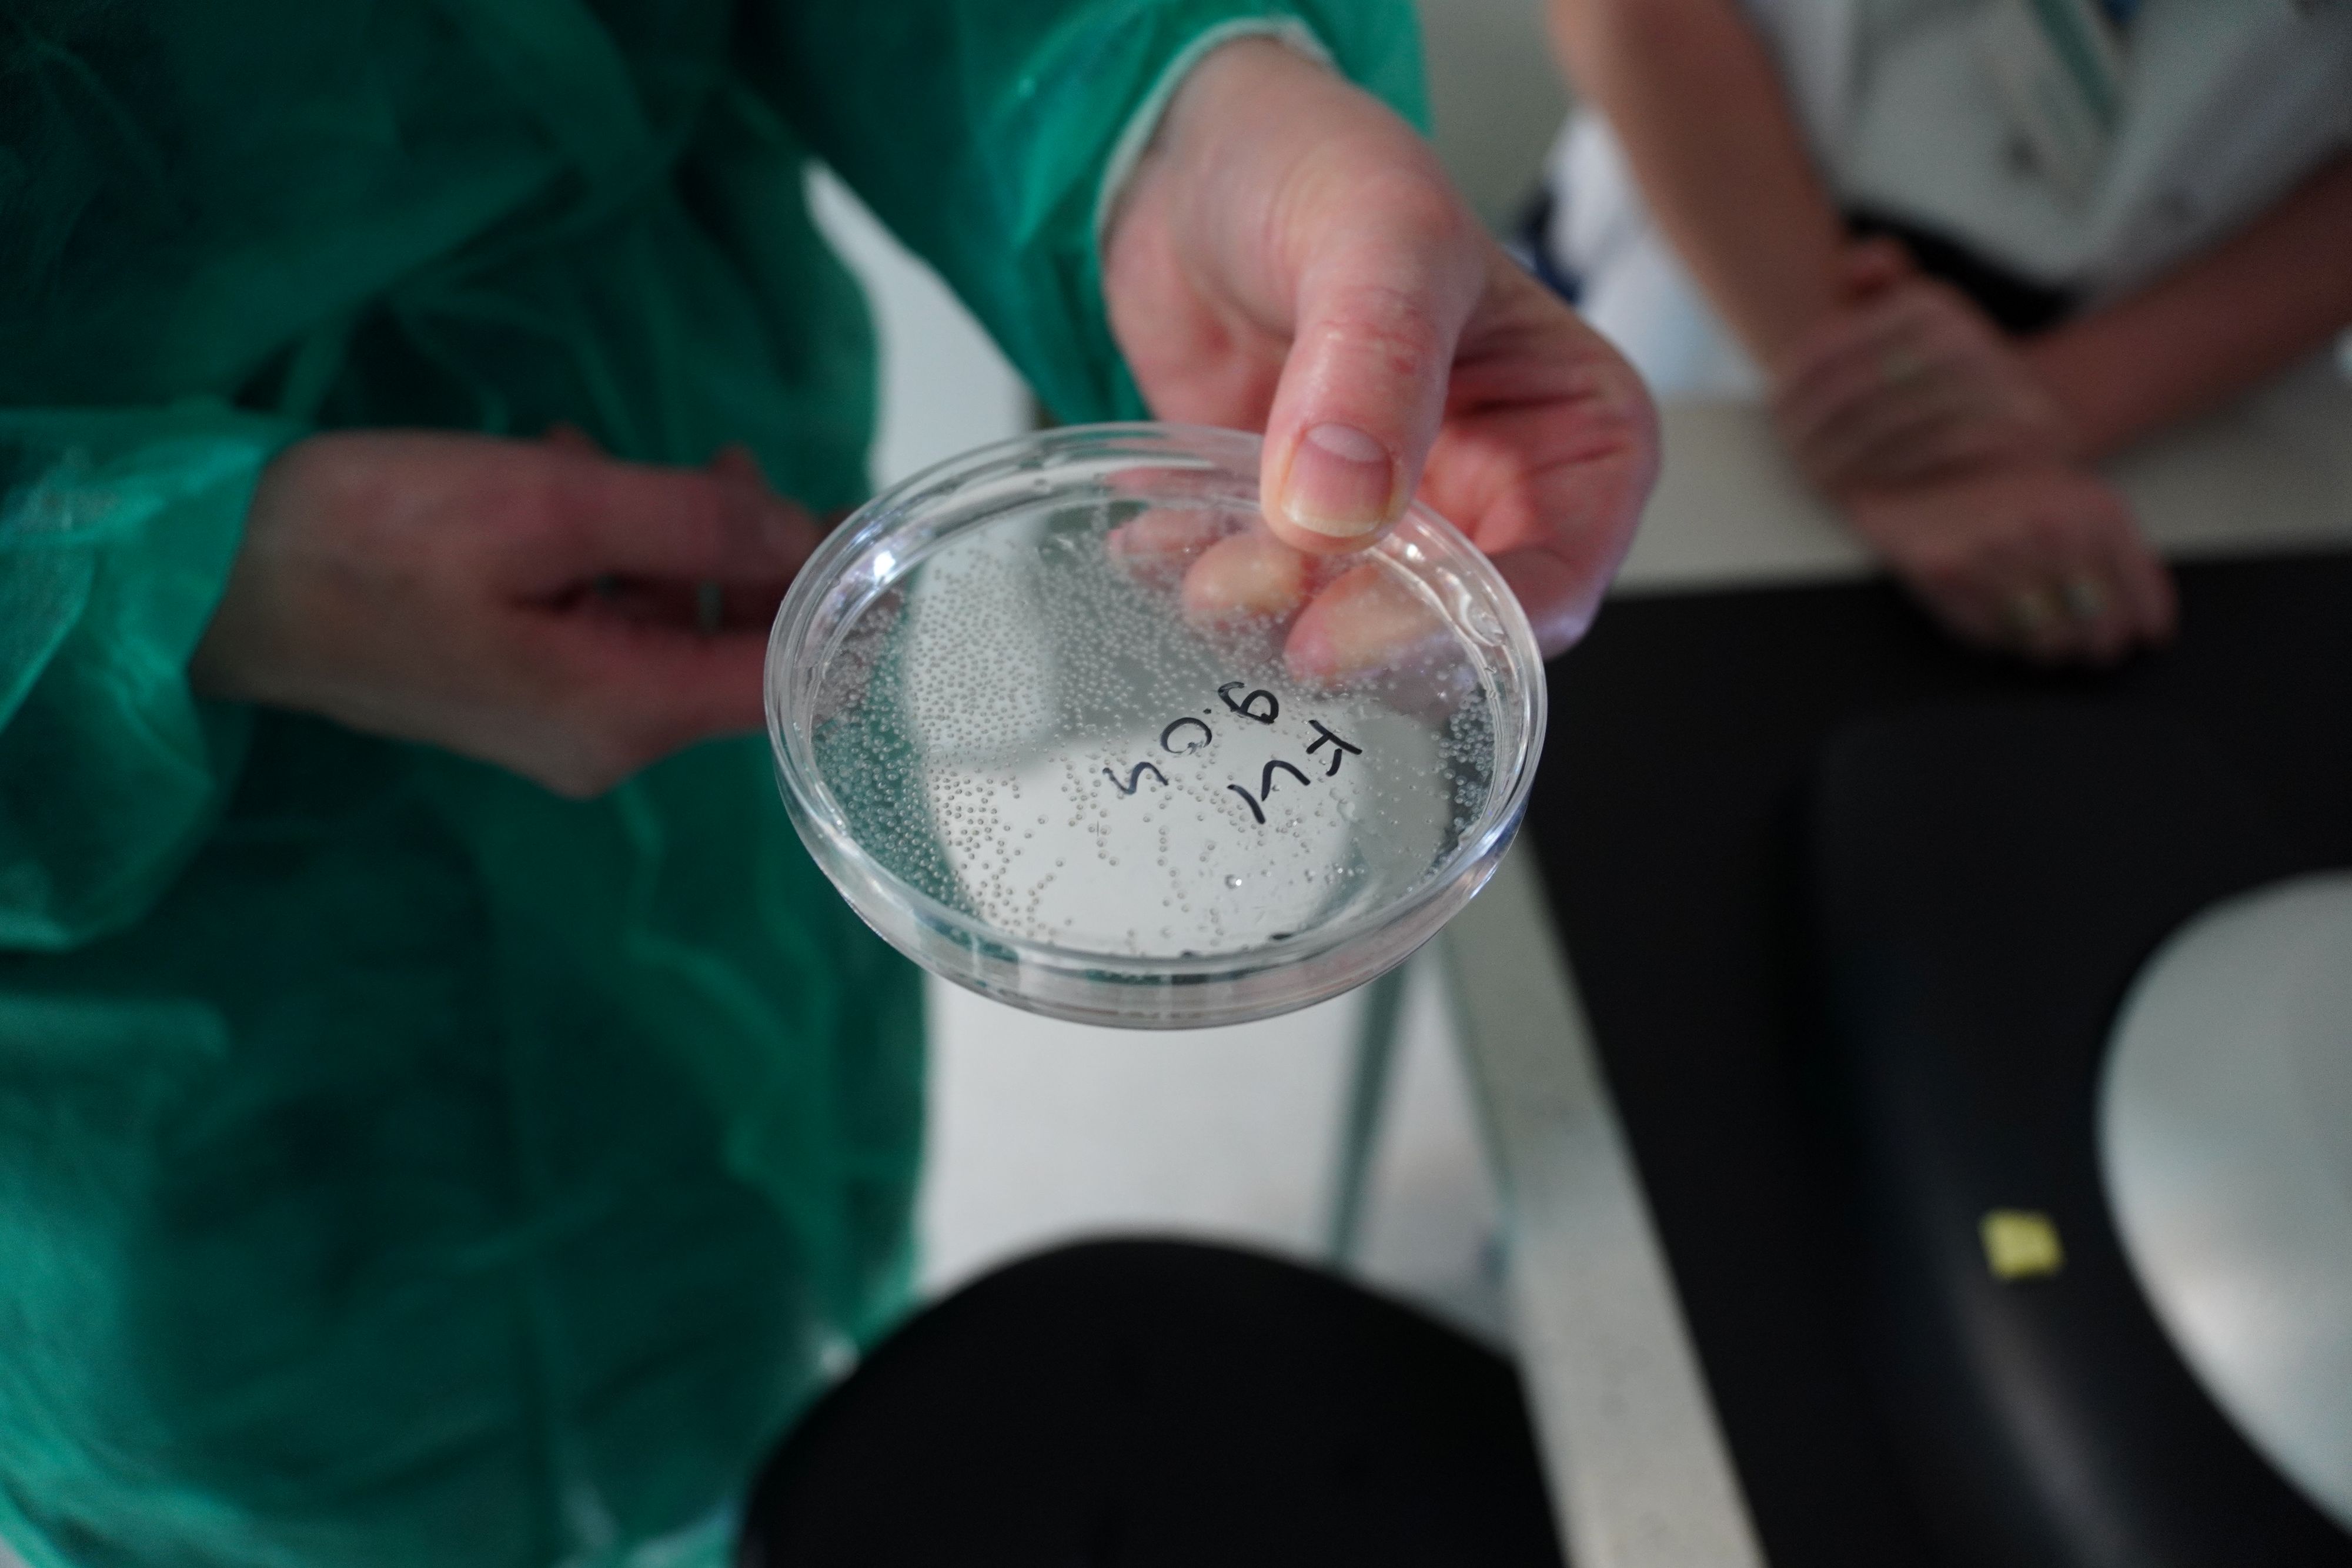

W czwartek 9 kwietnia Ośrodek Medycyny Doświadczalnej Uniwersytetu Medycznego w Lublinie po raz drugi zorganizował Dzień Otwarty, który w tym roku odbył się pod hasłem „Nauka–Klinika–Przemysł”. Wydarzenie miało na celu przybliżenie działalności Ośrodka, a także stworzenie przestrzeni do nawiązywania współpracy pomiędzy środowiskiem naukowym, klinicznym i przemysłowym.
Program dnia obejmował sesję wykładową z udziałem ekspertów reprezentujących różne dziedziny nauk biomedycznych. Spotkanie otworzył dr hab. Tomasz Trombik wykładem „OMD – misja i wizja”, w którym przedstawił główne założenia funkcjonowania Ośrodka oraz jego kierunki rozwoju. W kolejnych wykładach omawiano m.in. wykorzystanie modeli zwierzęcych i nowoczesnych technik analitycznych w poszukiwaniu bioaktywnych związków naturalnych (prof. Krystyna Skalicka-Woźniak) oraz zastosowanie organizmu modelowego zebrafish w badaniach biomedycznych (prof. Przemko Tylżanowski). Prof. Radosław Rola w wystąpieniu „Dlaczego klinicyście potrzebne są badania podstawowe” podkreślił znaczenie współpracy między nauką a praktyką kliniczną.
Istotnym elementem wydarzenia była możliwość zwiedzenia Ośrodka oraz bezpośrednich rozmów z badaczami. Uczestnicy mieli okazję zobaczyć laboratoria i infrastrukturę badawczą, na co dzień niedostępną dla osób, które nie prowadzą badań w OMD. Ta część spotkania cieszyła się dużym zainteresowaniem i sprzyjała wymianie doświadczeń oraz nawiązywaniu kontaktów.
Dzień otwarty został skierowany do szerokiego grona odbiorców – nauczycieli akademickich, badaczy, klinicystów, studentów oraz doktorantów zainteresowanych prowadzeniem badań naukowych. Jak podkreślił dr hab. Tomasz Trombik, celem inicjatywy jest otwarcie Ośrodka na współpracę nie tylko w obrębie uczelni, ale również z innymi instytucjami naukowymi oraz partnerami przemysłowymi. – „Ideą tego dnia jest otwarcie się na zewnątrz” – zaznaczył, dodając, że wydarzenie zostało szeroko skierowane także do partnerów spoza Uniwersytetu, w tym firm zainteresowanych realizacją badań komercyjnych.
OMD koncentruje swoje działania badawcze przede wszystkim w obszarze farmakologii i neurofarmakologii, badając wpływ substancji aktywnych na organizmy żywe z wykorzystaniem modeli zwierzęcych, takich jak gryzonie i zebrafish. Drugim ważnym kierunkiem są badania onkologiczne, obejmujące mechanizmy nowotworzenia oraz rozwój terapii przeciwnowotworowych. Jak wyjaśnił dr hab. Trombik, Ośrodek chce być miejscem, w którym badacze mogą kompleksowo realizować projekty – „Dążymy do tego, aby OMD stało się czymś w rodzaju hub-u naukowego, w którym połączymy różne podejścia badawcze wykorzystując modele od in vitro do in vivo”.
W trakcie spotkania poruszono również kwestie przyszłości badań in vivo. Zwrócono uwagę na konieczność ich odpowiedzialnego planowania oraz ograniczania wykorzystania zwierząt tam, gdzie jest to możliwe. – „To nie kompletna rezygnacja z badań in vivo, ale ograniczenie wykorzystania liczby zwierząt przez prawidłowe zaplanowanie i przeprowadzenie badania prowadzi do sukcesu naukowego” – podkreślił dr hab. Trombik. Jednocześnie zaznaczył, że w wielu obszarach badania z udziałem modeli zwierzęcych pozostają niezbędne dla rozwoju nowych terapii i zrozumienia mechanizmów chorób.
Dzień otwarty Ośrodka Medycyny Doświadczalnej pokazał, jak ważna jest integracja różnych środowisk wokół wspólnych celów badawczych. Wydarzenie stworzyło przestrzeń do dialogu, wymiany wiedzy oraz budowania współpracy, która może przełożyć się na rozwój nowoczesnych rozwiązań w medycynie i naukach pokrewnych.